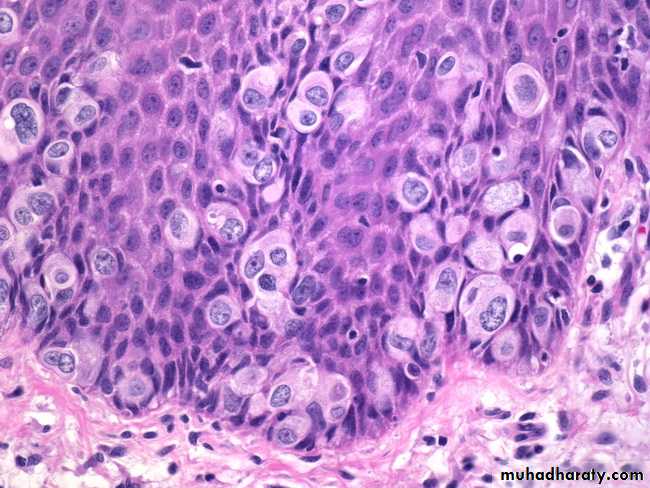

Female genital tract:-
Vulva:-I. Inflammatory condition ( vulvitis )
There are 2 types of vulval infections which are:-
1- Non-specific infections: by non-specific microbes which induced severe itching.
2- Specific infections: which are related to sexually transmitted diseases.
The two most important of these infectious agents are:
a- HPV infection producing condylomata acuminate and vulvar intraepithelial neoplasia.
b- HSV causing vesicular eruption.
Bartholin cysts: It's a common disorder occur in vulva due to obstruction of the excretory ducts of the glands.
II. Condylomas:
Which are anogenital warts, it's divided into 2 types:
1- Condylomata lata: caused by secondary syphilis and rarely seen today.
2- Condylomata acuminata: which is more common caused by HPV type (6 and 11) appears as papillary and elevated lesion, singly but more often in multiple sites, and identical lesions occur in men on the penis and around the anus in men and women. HPV 6 and 11 are low-risk viral types, and hence, vulvar condylomas do not commonly progress to cancer. However, women with condyloma acuminata are at risk of having other HPV-related lesions in the vagina and cervix.
Microscopically: appear in epidermal layer, the characteristic cellular feature is koilocytosis (a cytopathic change characterized by perinuclear cytoplasmic vacuolization and a wrinkled nuclear contour), a hallmark of HPV infection .
III-Carcinoma of vulva and vulvar intraepithelial neoplasia.
90% of carcinoma of vulva is SCC, the remainder are adenocarcinoma, melanoma or BCC.
It occurs usually in young age women 40-60 years old.
There are 2 biological forms of vulvar carcinoma, the 1st type occur in young age group and associated with HPV infection especially type 16 and 18 and preceded by vaginal , cervical carcinoma , carcinoma in situ or condylomata acuminata.
The vulvar intraepithelial neoplasia VIN usually graded according to its layer into grade I, II and III or called carcinomain situ, this condition remain many years or decades then develop invasive carcinoma by genetic, environmental factor as cigarette smoking or HPV infection.
2nd type occur in older age group, it's seen not associated with HPV infection.
Morphology:
Gossly: VIN and early vulvar carcinoma appear as areas of leukoplakia, then transformed into exophytic or ulcerative endophytic tumors.
Microscopically: HPV+ve neoplasms tend to be multifocal and poorly differentiated SCC, while HPV-ve lesions which are usually unifocal and well diffentiated keratinizing SCC, direct spread with deep invasion and regional LN involvement occur.
Extramammary Paget Disease
Paget disease is an intraepidermal proliferation of epithelial cells that can occur in the skin of the vulva or nipple of the breast . However, unlike in the breast, where Paget disease is virtually always associated with an underlying carcinoma, only a minority of cases of vulvar (extramammary) Paget disease have an underlying tumor. Instead, vulvar Paget cells most commonly appear to arise from epidermal progenitor cells. Paget disease manifests as a red, scaly, crusted plaque that may mimic the appearance of an inflammatory dermatitis. On histologic examination, large cells with abundant pale, finely granular cytoplasm and occasional cytoplasmic vacuoles infiltrate the epidermis, singly and in groups. Intraepidermal Paget disease may persist for years or even decades without evidence of invasion.
Vagina:
Inflammatory conditions ( Vaginitis )It's a common disorder producing vaginal discharge (leukorrhea), it's caused by bacteria, fungi and parasites.
The most common examples of fungi is
Candida albicans (monilia) produced white discharge, this organism present in about 5% of normal adults but appearance of symptomatic infection occur in lowering of immunity as in diabetic patients or sexually transmission of new aggressive strain.
T. vaginalis is example of parasitic infection produce watery, copious, grey-green discharge.
Tumors:-
Vaginal intraepithelial neoplasia and SCC.
These are uncommon lesions that usually occur in women over the age of 60, usually is preexisting or concurrent carcinoma of the cervix or vulva is present, however presence of HPV infection as a caucative agent is not well known but concurrence of this neoplasia with cervix and vulva suggest a common probably viral infection.
Other rare neoplasm of vagina is sarcoma botryoides (embryonal rhabdomyosarcoma ) occur usually in infants and children under the age of 5 years, it appear as soft polypoid masses.
Cervix:-
Cervicitis
Inflammation of cervix are common disorder and associated with mucopurulent vaginal discharge.
The infectious cervicitis is caused by variable specific and non specific microorganisms many of these microorganisms are transmitted sexually, the most important pathogen are C. trachomatis, herpetic infection and HPV.
We must differetaite true inflammatory cervicitis from so called "erosions", during development the columnar mucus secreting epithelium of the endocervix meets the squamous epithelial of ectocervix at the external os, in young women there's down-growth of the columnar epithelium below the ectocervical os-ectropian so squamocolumnar junction lie below exocervix, this exposed mucus-secreting columnar epithelium may appear reddened and moist and is mistakenly called cervical "erosion" but in elderly there's regrowth of the squamous epithelium up to the original external os. The area replaced by the squamous epithelium is known as the "transformation zone"
Tumors:-
Endocervical polyp:It appear as soft glistening polypoid mass protrude from endocervix and it's inflammatory in origin.
Microscopically: the lining epithelium of polyp and lining of glands consist of mucous secreting columnar epithelium, the stroma is oedematous and infiltrated by scattered mononuclear cells.
Cervical intraepithelial neoplasia (CIN) and squamous cell carcinoma.
Wide spread of papanicolaou (cytological) screening or pap smear has dramatically lowered the incidence of invasive tumor, because most or all of invasive cervical squamous cell carcinomas arise from precursor epithelial changes (CIN) but not all cases of CIN progress to invasive cancer, it may be regress, that's the precancerous epithelial changes (CIN) may precede the development of cancer by many years, so cellular atypia of squamous lining epithelium it's divided into 3 grades:
CIN grade I: Mild dysplasia.
CIN grade II: Moderate dysplasia.
CIN grade III: Severe dysplasia and carcinoma in situ and this according to level of dysplatic changes.
Pathogenesis:-
The prominent risk factors for the development of CIN and invasive carcinoma are:1- Early age at first intercourse.
2- Multiple sexual partners.
3- A male partner with multiple previous sexual partners.
4- Higher incidence in lower socioeconomic groups.
HPV infection can be detected in higher percentage of precancerous lesions and invasive neoplasms, especially type 16 and 18 in these lesions viral DNA integrate into the cellular genome and endcode proteins that block or inactivate tumor suppressor genes P53 and Rb in target epithelial cells and this causing uncontrolled proliferations of cells.
However not all women infect by this virus develop SCC but this need another carcinogens as lowering immunity or cigarette smoking.
Invasive carcinoma of the cervix:-
SCC is most common type of invasive carcinoma of cervix which is form 80-95% of all cases, other rare form are adenocarcinoma and other types, this is usually arise from CIN by many years may be reached 10-15 years other cases especially in high grade CIN may be shorter interval to develop invasive carcinoma.
Morphology:-
Grossly: invasive carcinoma takes one of three forms it's either:
1- Fungating tumor that may develop to cauliflower-like mass.
2- Ulcerative form characterized by sloughing of the central surface of the tumor.
3- Infiltrative which tend to grow downward to stroma. These tumors usually spread locally downward and upward to uterus, broad ligament, rectum, base of bladder and even the ureters. Then with progress can spread by LN or hematogenous distant metastasis.
Histology:
SCC is graded according to differentiation of tumor cells into 3 grades:Grade I: in well differentiated keratinizing type.
Grade II: in moderately differentiated type.
Grade III: in poorly differentiated type.
While staging system according to its dissemination.